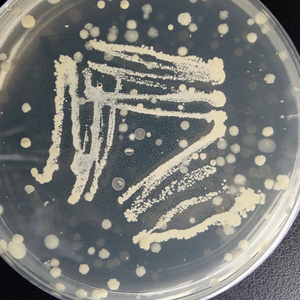
ssaw

SSAW
東京事変
ssaw
Saiakoup

SSAW
東京事変

SSAW(ss/aw)
東京事変

广顺2025 Cypher
秃子2z, 金剑GOLDENSWORD, 赵山河, YUNG SSAW, 辉子

SSAW(翻自 东京事变)
电弃都市乐队

Ssaw
李硕

SSAW
CHERU

Round and Round(Cover)
itsevahere

秋
BTRUESAD, CroissantKX

四季(prodbyredrunmusic)
BTRUESAD

SSAW1 Free
Tomboy

SSAW
EG

SO ICY 冰冷至深
周赫朗·P猪, YUNG SSAW

地心引力
YUNG SSAW, 赵山河, Mok

深夜Night Time
PinkPear, YUNG SSAW

A1
YUNG SSAW, 赵山河

欢迎光临(Ft.YUNG SSAW)
陈霖璋, YUNG SSAW

深渊
金剑GOLDENSWORD, YUNG SSAW

龙虎斗
YUNG SSAW

嫉妒
YUNG SSAW, 黑先生

Slow down
YUNG SSAW, 黑先生

PEIN 佩恩
周赫朗·P猪, YUNG SSAW

香格里拉
YUNG SSAW

玛利亚 Maria
YUNG SSAW, 金剑GOLDENSWORD

那女人 ft.YUNG SSAW
Mon.K, YUNG SSAW

VVS
Jelly Drop大宇, PinkPear, YUNG SSAW

NOSEBLEED 流鼻血
周赫朗·P猪, YUNG SSAW

广顺2020cypher
广顺, 赵山河, YUNG SSAW, 金剑GOLDENSWORD, 秃子2z

颠倒
YUNG SSAW, 泽, PlanZ普蘭茲一